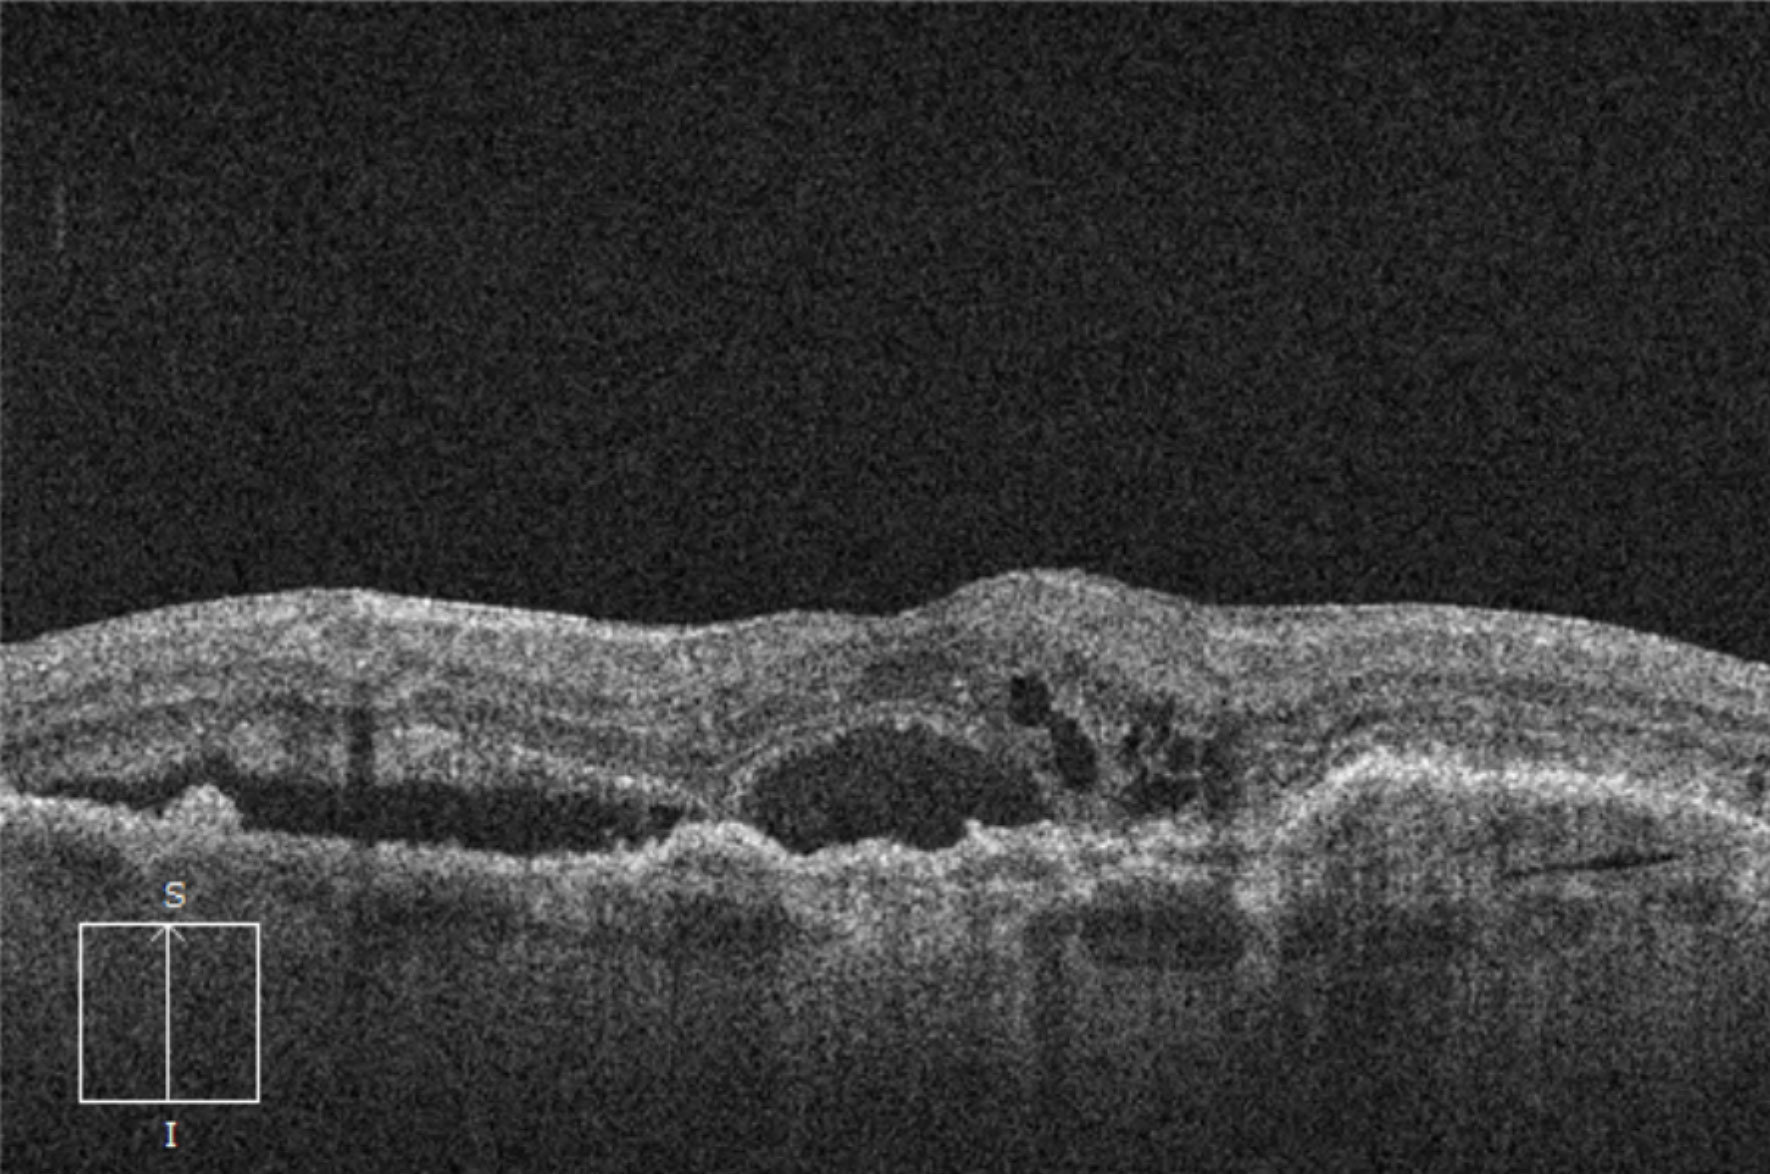
Keystone Exercises using Static Images

Macular OCT Interpretation: Course 101
Identify critical landmarks and explore key terms as you begin your journey to master OCT interpretation.
Macular OCT Interpretation: Course 201
Practice identifying vitreoretinal interface pathology to enhance your OCT foundation.
Macular OCT Interpretation: Course 301
Move beyond interpretation and delve into diagnostics by understanding OCT patterns.
Macular OCT Interpretation: Course 401
Journey into advanced terminology to continue your path toward OCT expertise.
Keystone Exercises using Static Images
Practice identifying features in OCTs without any hints.
OCT-A 101
Begin your OCT-A journey with this video-based tutorial.
OCT-A 201
Identify critical landmarks and delve into slab analysis to ground your OCT-A interpretation skills.
Glaucoma OCT Interpretation: Course 101
Read optic nerve OCTs like an expert with just a few weeks of practice.
Atlas of Retinal Disease
A searchable index of commonly encountered retinal diseases...and a few rare ones too!
Macular OCT Glossary
This glossary is a selection of the terms you will encounter while using Interpret: Macular OCT.